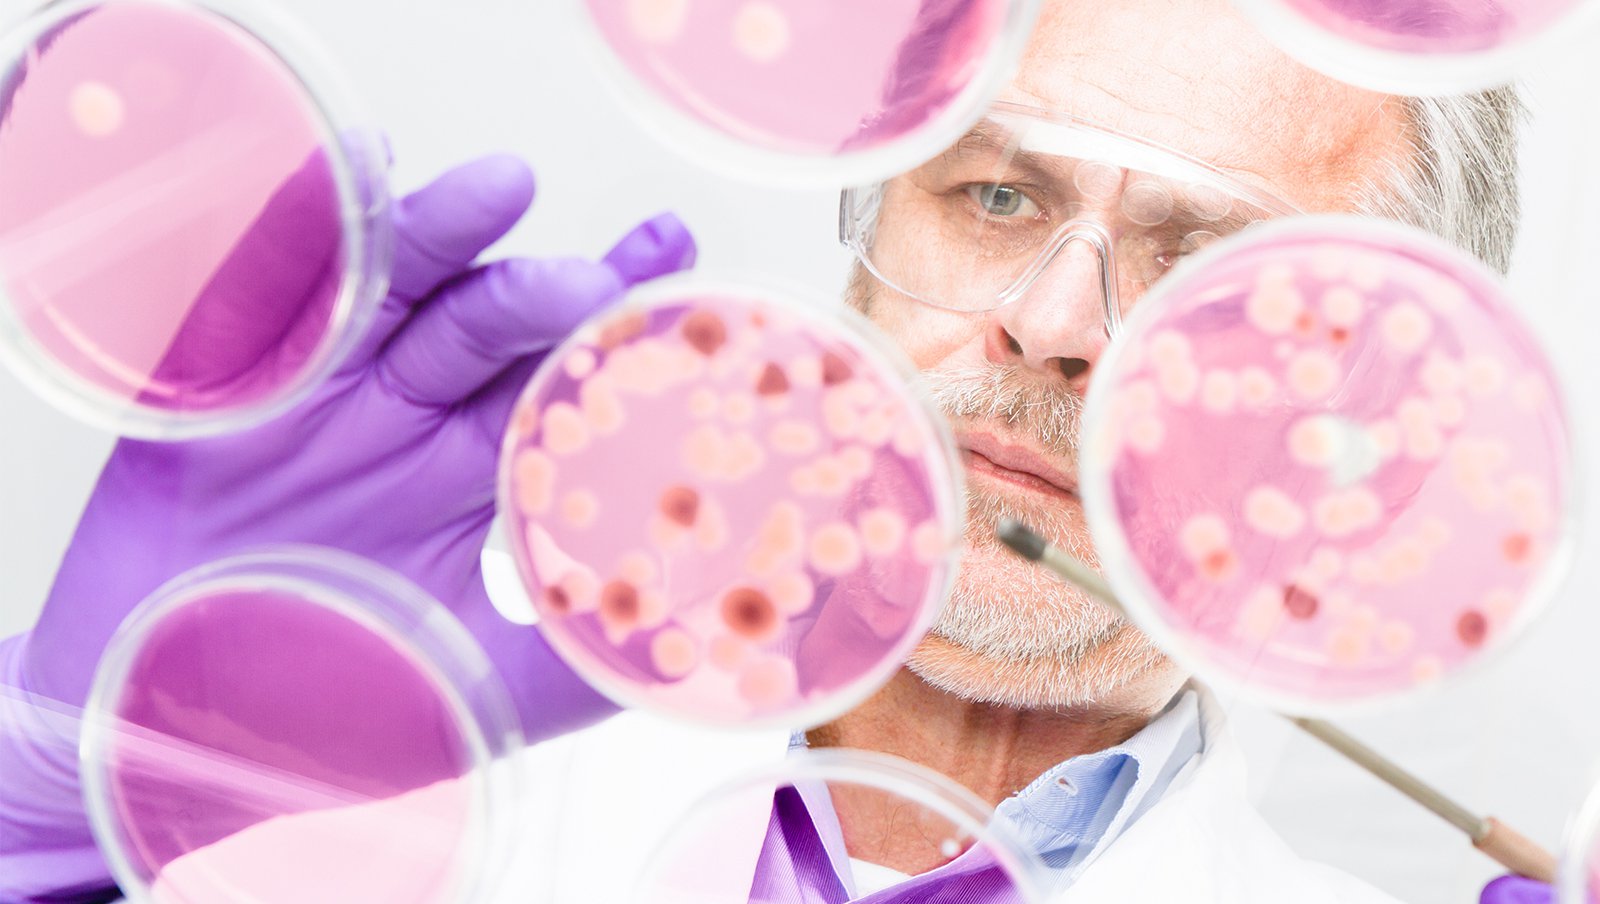
Powikłania infekcyjne - rzadsze oblicza grzybicy. Fuzarioza

Inwazyjne zakażenia grzybicze u pacjentów z nowotworami hematologicznymi, zwłaszcza przy występującej jednocześnie neutropenii z gorączką, stanowią poważne zagrożenie i cechują się wysoką śmiertelnością. Aspergiloza, kandydoza, fuzarioza, mukormykoza, kryptokokoza i trichosporonoza należą do najczęstszych infekcji w przypadku tych chorych.
Materiał przeznaczony wyłącznie dla pracowników służby zdrowia
Ten materiał jest dostępny dla zarejestrowanych użytkowników.
Zaloguj się
Szanowni użytkownicy,
część materiałów udostępnianych na naszym portalu jest przeznaczona
wyłącznie dla lekarzy.
Wynika to z regulacji prawnych, do których musimy się stosować.
Jeśli nie jesteś lekarzem, zachęcamy do korzystania z przygotowanych przez nas materiałów dostępnych w zakładce dla pacjentów.







